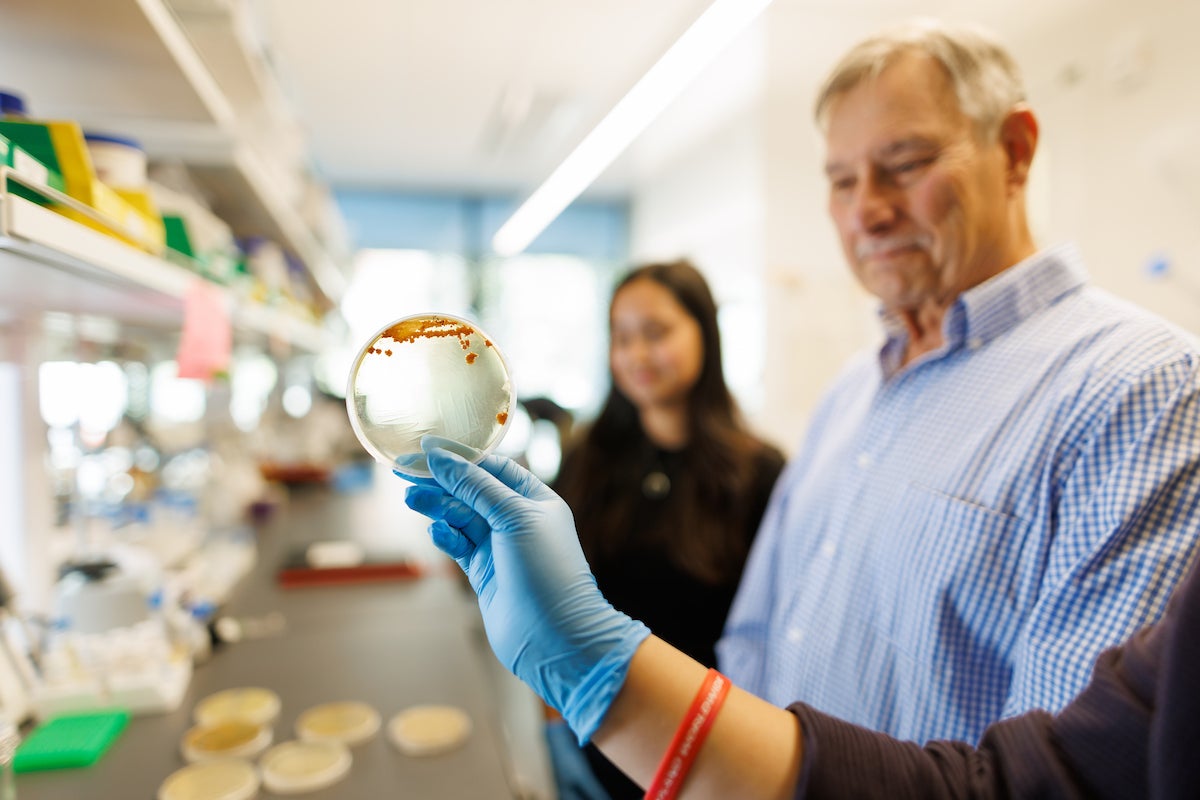
A hand holds a petri dish in front of a professor's face.

Cal Poly Scientists Look to Ancient Microbes to Discover the Antibiotics of the Future

A quest to discover new antibiotics is taking a Cal Poly biochemistry research team back in time millions of years as they study ancient microorganisms.
Research led by biochemistry professor Katharine Watts and Rachel Johnson, a Frost teacher-scholar postdoctoral fellow, involves intensive study of a library of ancient microbial strains that are approximately 25 to 40 million years old.
Professor emeritus Raul Cano, a renowned microbiologist, who once worked with the scientist who inspired Michael Crichton’s 1990 novel “Jurassic Park” novel, donated his collection of 93 prehistoric bacteria strains to Watts for research.
The collection includes strains extracted from amber, as well as other sources such as ocean floor sediment samples from the Gulf of Mexico. The team hopes the work will provide insights into potential benefits for modern medicine.
“It’s extremely exciting to have this rare chance to work with a treasure trove of ancient bacteria, which could be very different from those living in the modern environment,” Watts said. “Many antibiotics on the market were originally discovered from bacteria that naturally produce them. Our goal is to screen which ancient strains may produce something like an antibiotic and then gather genomic information that can help us understand how it’s being made.”
Their research comes amid the rise of antibiotic-resistant pathogens that can render medications ineffective in treating diseases such as pneumonia, urinary tract infections, sepsis, skin inflammations, foodborne illnesses and others. Many scientists are looking for new antibiotic molecules that could work against pathogenic bacteria that have gained resistance to existing drugs. The key could be investigating underexplored microbes, like those from the ancient library, for antibiotic production.
Another goal of the research is to gain a deeper understanding of antibiotic resistance.

“We’re also testing these ancient microbes for their ability to survive treatments of modern antibiotic compounds,” Johnson said. “Through these screenings, we can go back in history and answer questions like, ‘What were these bacteria resistant to back then?’ and ‘How has antimicrobial resistance evolved?’”
Scientists have successfully cultured over 30 microbes and are checking whether the compounds they make act as antibiotics against lab-safe bacteria that mimic disease-causing pathogens. The researchers have already identified seven bacteria strains that exhibit antibacterial activity, but the chemical structures of the antibiotic molecules remain to be determined.
Another strain showed resistance to apramycin, a known antibiotic used in veterinary medicine to treat animal infections. Bacteria protect themselves against antibiotics they produce; so it is possible that the strain produces apramycin or a closely related molecule. It may have evolved resistance against apramycin for another reason.

Genetic analyses will help point to structures of these antibiotic compounds, as well as potential resistance mechanisms. The unusual opportunity arose because Cano collected the strains decades ago. He isolated microorganisms from the guts of bees and soil trapped in ancient amber, highlighted in a 2009 article in WIRED magazine that reported on his extractions from fossilized amber. Cano used 45-million-year-old yeast as an ingredient in a craft beer that he calls Fossil Fuels.
Cano, a native of Cuba who became the first Cuban-American inducted into the Academy of Sciences in Cuba in 2024, taught at Cal Poly from 1974 to 2005. He became interested in extracting DNA from fossils after working with George O. Poinar Jr., an entomologist (focusing on study of insects) whose work inspired author Crichton to publish the science-fiction novel “Jurassic Park,” which spawned an award-winning 1993 film adaptation from director Steven Spielberg and a string of five sequels.
In 1993, the pair collaborated with other scientists to extract DNA from a 125-million-year-old

Lebanese weevil (a small beetle with a long snout) preserved in amber. Cano’s collection includes more than 40 different strains of bacteria from amber, which are stored at a temperature of negative 80°C (−112°F). The bacteria are grown near room temperature with traditional nutrients for modern lab bacteria for ongoing studies.
While the Cal Poly team is in the research and discovery stages, there are no current plans to design a drug, which would likely require significant additional financial investment and industry partnerships, as well as further scientific study. But the research could provide new structures for antibiotic development and clues into how resistance mechanisms arise.
Student participants have been funded through the university’s BEACoN program, supporting underrepresented students in research. Cal Poly’s Research, Scholarly and Creative Activities Grants program has also provided student support as well as supplies and materials.

“Working with bacteria strains from millions of years ago is surreal,” said Safiya Rufino, a BEACoN research scholar double majoring in food science and microbiology as she explores new ways to advance food safety and combat antimicrobial resistance. “These bacteria samples have lived during a time we can only know through carbon dating. It also makes me wonder how it would be to one day be revived millions of years in the future, how would I react, would I still be able to function as I once did as these bacteria are able to?”
Added Kaitlyn Calligan, a microbiology major and BEACoN research scholar: “It’s really fun to have so many various strains of bacteria at our disposal. They appear bright yellow, pink, matte white, or have interesting colony formations. Researching them truly is never boring.”
Want more Learn by Doing stories in your life? Sign up for our monthly newsletter, the Cal Poly News Recap!




